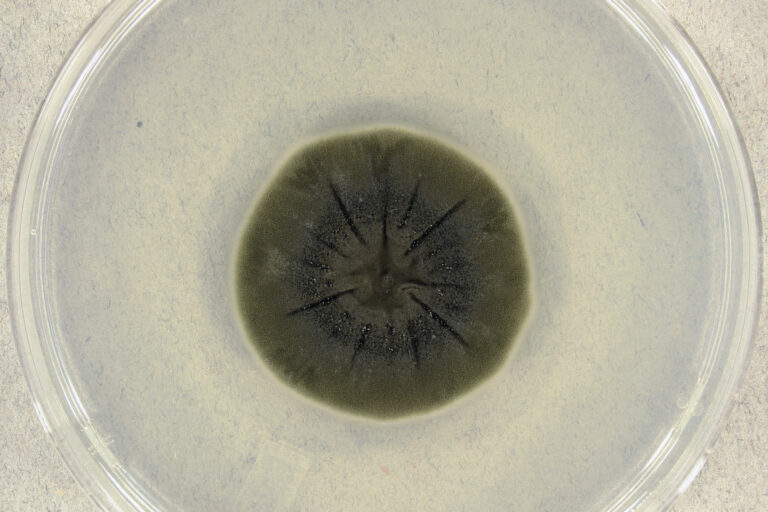
Koloni jamur hitam Cladosporium sphaerospermum | CC BY-SA 4.0

-
Ledakan Reaktor Chernobyl 1986 mengakibatkan pelepasan material radioaktif yang luas, mencemari lingkungan dan memaksa evakuasi besar-besaran, sementara di zona eksklusi, kehidupan menemukan cara bertahan, salah satunya melalui jamur Cladosporium sphaerospermum yang berkembang meski terpapar radiasi ekstrem.
-
Jamur radiotrofik seperti Cladosporium sphaerospermum memanfaatkan radiasi gamma sebagai sumber energi melalui mekanisme yang disebut radiotropisme, mirip dengan proses fotosintesis pada tumbuhan. Penelitian ilmiah menunjukkan bahwa jamur ini mengalami pertumbuhan lebih cepat di lingkungan dengan radiasi tinggi dibandingkan dengan yang tumbuh di lingkungan normal.
-
Potensi bioremediasi jamur di zona Chernobyl mencakup kemampuan untuk mengakumulasi dan mengurai radionuklida, yang dapat mengurangi kontaminasi radioaktif. Penelitian lebih lanjut diperlukan untuk memahami dampak ekologis jangka panjang serta potensi aplikasi teknologi bioremediasi di masa depan.
Pada 26 April 1986, dunia diguncang oleh ledakan dahsyat di Reaktor Nomor 4 Pembangkit Listrik Tenaga Nuklir Chernobyl, Ukraina. Kejadian ini tidak hanya mencatatkan salah satu bencana nuklir paling mengerikan dalam sejarah, tetapi juga meninggalkan warisan radiasi yang mematikan di sekitarnya. Ledakan tersebut melepaskan jumlah material radioaktif yang sangat besar, mencemari udara, tanah, dan air, serta memaksa evakuasi ratusan ribu orang dari zona sekitar reaktor. Dalam beberapa detik, kehidupan di sekitar Chernobyl berubah selamanya, dan dampak lingkungan serta kesehatan jangka panjangnya terus dirasakan hingga kini.

Di tengah kehancuran dan kontaminasi yang meluas ini, saat dunia melihat hanya reruntuhan dan kehancuran, sebuah fenomena tak terduga mulai muncul. Di zona eksklusi Chernobyl, yang diselimuti radiasi mematikan, kehidupan justru menemukan cara untuk bertahan, bahkan berkembang. Salah satu penemuan paling mengejutkan adalah kemampuan jamur hitam Cladosporium sphaerospermum untuk tumbuh subur meski terpapar radiasi ekstrem. Jamur ini mampu memanfaatkan radiasi gamma sebagai sumber energi, membuka peluang baru dalam riset bioremediasi dan teknologi perlindungan radiasi.
Penemuan Jamur Hitam di Chernobyl
Penelitian awal pada akhir 1980-an dan awal 1990-an oleh ilmuwan Ukraina setelah bencana Chernobyl membuka wawasan baru tentang mikroorganisme yang mampu bertahan hidup dalam radiasi mematikan. Di dalam reaktor Nomor 4 yang rusak dan kolam air radioaktif di sekitarnya, mereka menemukan jamur hitam yang tumbuh subur di tengah paparan radiasi tinggi.
Analisis lebih lanjut mengidentifikasi jamur tersebut sebagai Cladosporium sphaerospermum. Temuan ini memunculkan pertanyaan mengenai bagaimana kehidupan dapat berkembang di lingkungan yang mematikan bagi sebagian besar makhluk hidup, termasuk manusia. Keberadaan jamur yang tumbuh ke arah radiasi gamma tertinggi (radiotropisme) memberikan petunjuk bahwa ini bukan sekadar kelangsungan hidup pasif, tetapi merupakan interaksi aktif dengan sumber radiasi. Selama 15 tahun berikutnya, ribuan strain dari berbagai spesies mikrofungi diisolasi dari dalam dan sekitar lokasi bencana, menunjukkan adaptasi jamur yang lebih luas terhadap radiasi.
Baca Juga: Menakar Penggunaan Energi Nuklir dan Risikonya Bagi Lingkungan
Radiotropisme: Mengubah Radiasi Menjadi Energi – Metabolisme Unik Jamur Chernobyl
Konsep radiotropisme menggambarkan kemampuan organisme untuk memanfaatkan radiasi pengion sebagai sumber energi untuk metabolisme. Dalam kasus Cladosporium sphaerospermum dan jamur lainnya yang ditemukan di Chernobyl, radiasi gamma berfungsi sebagai sumber energi, mirip dengan bagaimana tumbuhan menggunakan sinar matahari untuk fotosintesis. Proses ini, yang terkadang disebut radiosintesis, memungkinkan jamur untuk mengubah energi radiasi gamma menjadi energi kimia yang mendukung pertumbuhan dan reproduksi.
Penelitian yang dilakukan menunjukkan bahwa jamur tertentu di Chernobyl tidak hanya mampu bertahan terhadap radiasi, tetapi juga memanfaatkannya untuk mempercepat pertumbuhannya, terutama dalam kondisi terbatas nutrisi. Fenomena radiotropisme, di mana jamur menunjukkan pertumbuhan hifa terarah menuju sumber radiasi gamma, semakin memperkuat hipotesis bahwa jamur ini memanfaatkan radiasi sebagai sumber energi.

a) gambar mikroskopi cahaya dari “hantu” melanin C. neoformans; (b–e) gambar TEM dari “hantu” C. sphaerospermum yang berasal dari sel yang tumbuh pada media kaya nutrisi atau media kekurangan nutrisi: b) agar dextrose kentang; c) agar dextrose Sabaroud; d) agar air dengan kasein; e) agar air dengan dextrose. Perbesaran asli: gambar mikroskopi cahaya – X 1.000; gambar TEM – X 13.000 | https://doi.org/10.1371/journal.pone.0000457.g001
Penelitian dalam jurnal PLOS ONE memberikan bukti ilmiah mengenai fenomena radiotrofik ini. Penelitian tersebut menunjukkan bahwa jamur seperti Cladosporium sphaerospermum yang tumbuh di lingkungan dengan radiasi tinggi mengalami peningkatan laju pertumbuhan dibandingkan dengan yang tumbuh di lingkungan normal. Penelitian ini membuka jalan bagi para ilmuwan untuk memahami bagaimana mekanisme biokimiawi dalam jamur hitam mampu mengubah radiasi menjadi energi yang berguna bagi kehidupan.
Melanin: Pigmen Multifungsi dalam Adaptasi Radiasi
Melanin, pigmen yang memberikan warna gelap pada kulit manusia dan organisme lainnya, memainkan peran penting dalam kemampuan Cladosporium sphaerospermum dan jamur radiotrofik lainnya untuk beradaptasi dengan lingkungan radiasi Chernobyl. Di dalam jamur ini, melanin tidak hanya melindungi dari efek merusak radiasi pengion, tetapi juga berfungsi untuk menyerap dan mengonversi radiasi menjadi energi yang dapat digunakan.
Penelitian menunjukkan bahwa melanin dalam jamur radiotrofik mampu menyerap radiasi elektromagnetik, termasuk sinar gamma. Mekanisme transduksi energi yang diusulkan melibatkan perubahan sifat elektronik melanin akibat radiasi pengion, memungkinkan pigmen ini berfungsi dalam proses transfer energi dan elektron. Penelitian lebih lanjut juga mengungkapkan bahwa melanin dapat terus teroksidasi saat terpapar radiasi gamma, menghasilkan arus listrik dan memberikan bukti lebih lanjut akan kemampuannya dalam konversi energi.
Potensi Aplikasi dalam Bioremediasi Limbah Radioaktif
Jamur Cladosporium sphaerospermum dan spesies lainnya yang ditemukan di Chernobyl memiliki potensi besar untuk digunakan dalam bioremediasi limbah radioaktif. Jamur ini mampu menyerap dan mengakumulasi radionuklida seperti Cesium-137, secara efektif menghilangkannya dari lingkungan. Beberapa jamur juga dapat menguraikan bahan radioaktif berbasis karbon, seperti grafit dari inti reaktor, yang berpotensi mengurangi kontaminasi.
Baca juga: Bagaimana Jika Limbah Nuklir Dibuang ke Angkasa, Atau Matahari?
Dampak Ekologis Jangka Panjang di Zona Eksklusi Chernobyl
Keberadaan dan aktivitas jangka panjang jamur radiotrofik di zona eksklusi Chernobyl kemungkinan memiliki dampak signifikan terhadap ekosistem lokal. Peran mereka dalam dekomposisi bahan radioaktif, seperti puing-puing reaktor dan materi organik yang terkontaminasi, dapat memengaruhi siklus radionuklida dalam lingkungan. Imobilisasi radionuklida oleh biomassa jamur di dalam tanah dapat memengaruhi ketersediaannya bagi organisme lain dalam rantai makanan.
Interaksi potensial antara jamur ini dengan mikroorganisme lain dan bahkan tumbuhan di zona eksklusi masih dalam penyelidikan. Dominasi spesies jamur yang mengandung melanin di lokasi yang sangat terkontaminasi menunjukkan bahwa mereka memainkan peran ekologis yang signifikan di daerah ini. Namun, beberapa penelitian juga menunjukkan bahwa jamur dapat mengakumulasikan berbagai radionuklida, termasuk radiocesium, yang berpotensi menyebabkan transfer radionuklida ke atas rantai makanan jika jamur ini dikonsumsi oleh hewan.
Baca juga: 32 Tahun Ledakan Reaktor Nuklir Chernobyl, Ini Kondisi Terkini Lingkungan Sekitarmya
Dekomposisi bahan radioaktif oleh jamur ini menunjukkan bahwa mereka memainkan peran dalam atenuasi kontaminasi alami di zona eksklusi, meskipun skala waktu dan efektivitas keseluruhan dari proses ini masih dalam penyelidikan. Bioremediasi alami ini dapat berkontribusi pada pemulihan jangka panjang ekosistem Chernobyl. Imobilisasi radionuklida oleh jamur dapat memiliki efek kompleks pada ekosistem, berpotensi mengurangi penyebaran kontaminasi, namun juga memusatkannya dalam biomassa jamur, dengan konsekuensi yang tidak pasti bagi organisme yang berinteraksi dengan jamur ini. Memahami nasib radionuklida yang terakumulasi dalam rantai makanan sangat penting untuk menilai dampak ekologis secara keseluruhan.
Dominasi jamur bermelanin di daerah yang sangat radioaktif menunjukkan bahwa mereka adalah komponen kunci dari komunitas mikroba di lingkungan ekstrem ini, kemungkinan memengaruhi siklus nutrisi dan proses ekologis lainnya. Kelimpahan mereka menunjukkan bahwa mereka memiliki peran ekologis yang signifikan di zona eksklusi Chernobyl, dan penelitian lebih lanjut diperlukan untuk sepenuhnya memahami interaksi mereka dengan organisme lain dan lingkungan.













